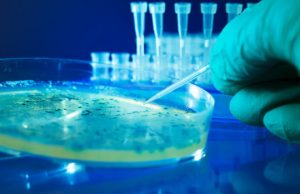
How E. coli knows how to cause the worst possible infection How E. coli knows how to cause the worst possible infection

science
‘100-year’ floods will happen every 1 to 30 years, according to...
A 100-year flood is supposed to be just that: a flood that occurs once every 100 years, or a flood that has a one-percent...
Cracking a decades-old test, researchers bolster case for quantum mechanics
In a new study, researchers demonstrate creative tactics to get rid of loopholes that have long confounded tests of quantum mechanics. With their innovative...
The case for retreat in the battle against climate change
When it comes to climate change, moving people and development away from at-risk areas can be viewed, not as a defeat, but as a...
Scientists successfully innoculate, grow crops in salt-damaged soil
A group of researchers may have found a way to reverse falling crop yields caused by increasingly salty farmlands throughout the world.
Led by Brent...
Maximum mass of lightest neutrino revealed using astronomical big data
Neutrinos come in three flavours made up of a mix of three neutrino masses. While the differences between the masses are known, little information...
An Ice Age savannah corridor let large mammals spread across Southeast...
New research from the University of Tübingen indicates that the Thai-Malay Peninsula—where parts of Malaysia, Myanmar and Thailand are located—was at least partly an...
Generation of light in a photon-number quantum superposition
Physicists at C2N have demonstrated for the first time the direct generation of light in a state that is simultaneously a single photon, two...
Is it autism? The line is getting increasingly blurry
Around the world, the number of people diagnosed with autism is rising. In the United States, the prevalence of the disorder has grown from...
Wearable sensors detect what’s in your sweat
Needle pricks not your thing? A team of scientists at the University of California, Berkeley, is developing wearable skin sensors that can detect what's...
How E. coli knows how to cause the worst possible infection
A pair of University of Virginia School of Medicine scientists have revealed how E. coli seeks out the most oxygen-free crevices of your colon to cause...
Studying quantum phenomena in magnetic systems to understand exotic states of...
Besides solids, liquids and gases, more exotic states of matter can be generated in specific materials under special conditions. Such states are of great...